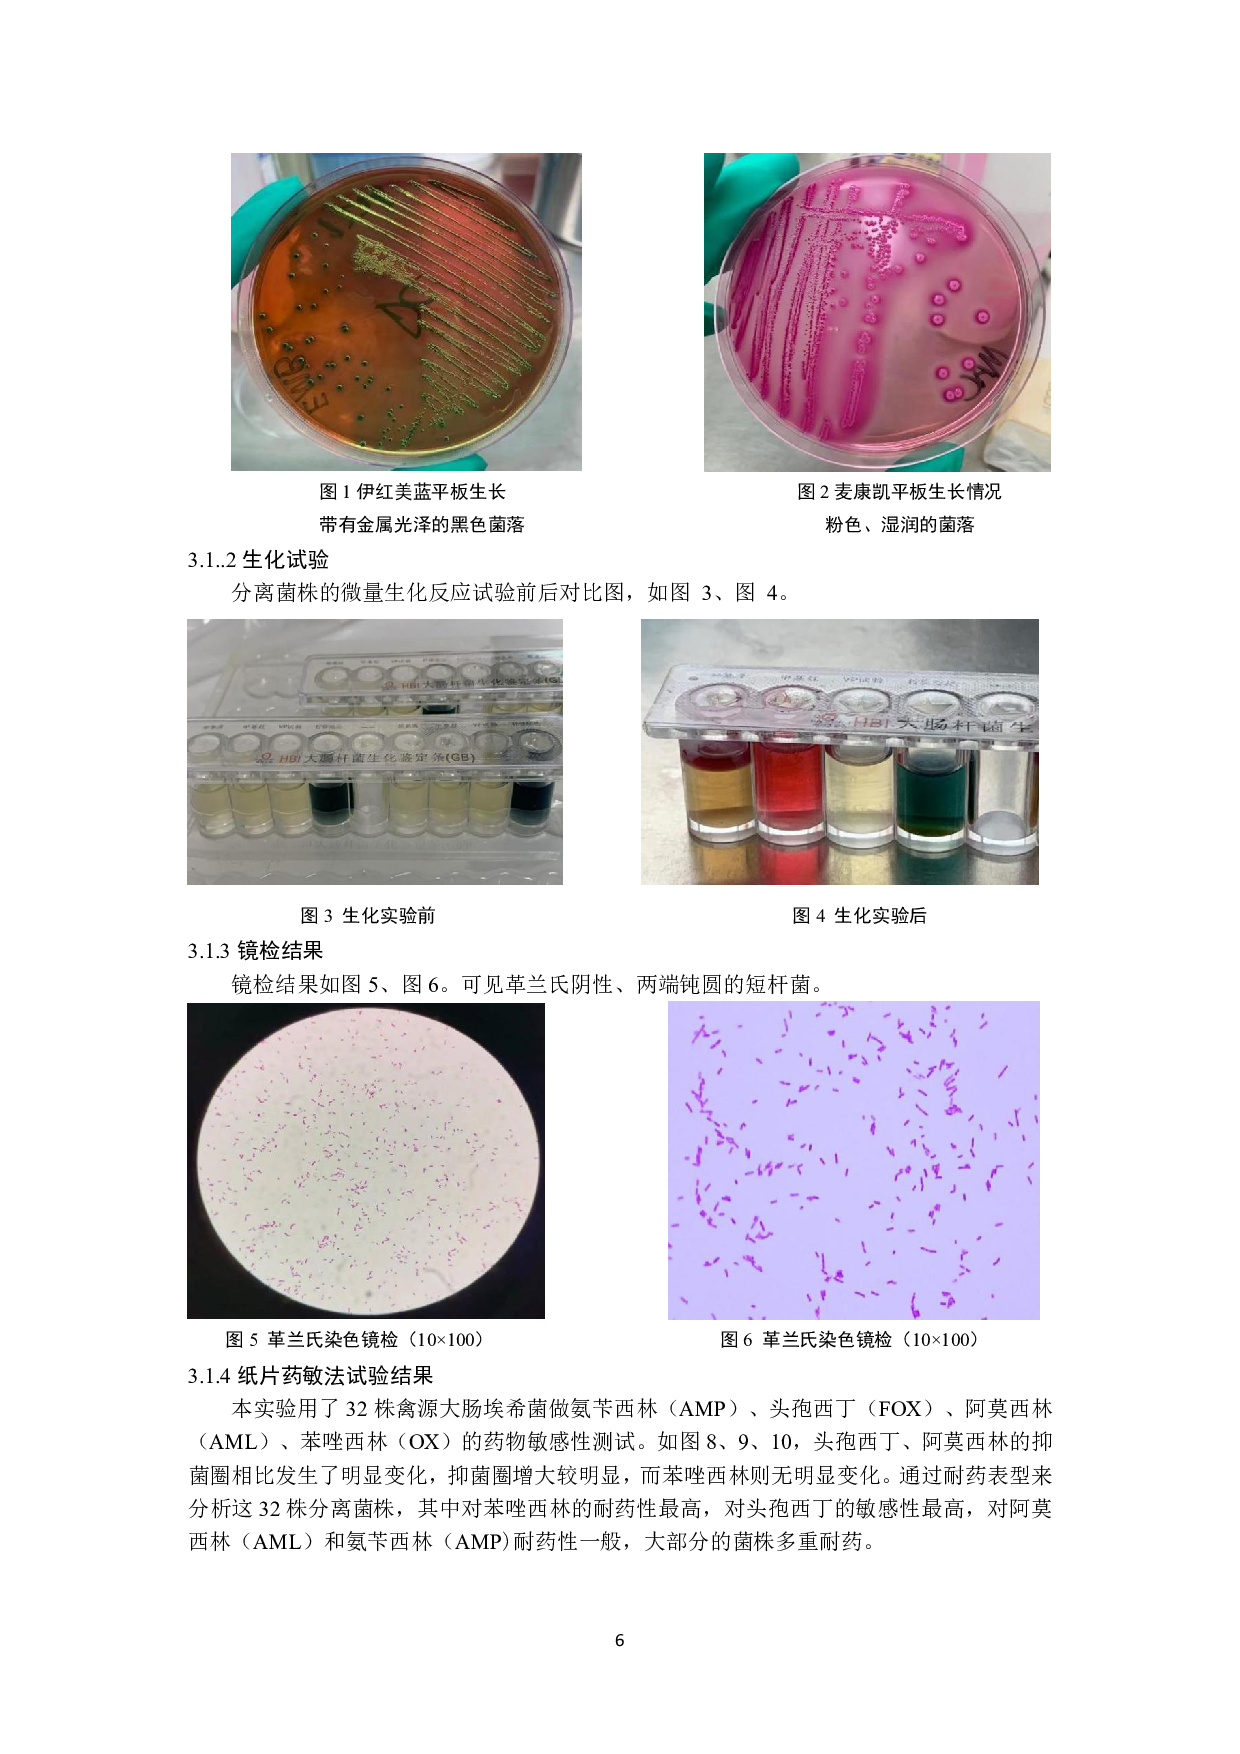
禽源大肠杆菌对&beta;-内酰胺类药物的耐药分析-7234字.pdf 第8页

II
目录
摘要.....................................................................................................................................................1
前言.....................................................................................................................................................1
1文献综述..........................................................................................................................................1
1.1抗生素的现状..................
禽源大肠杆菌对β-内酰胺类药物的耐药分析-7234字.pdf